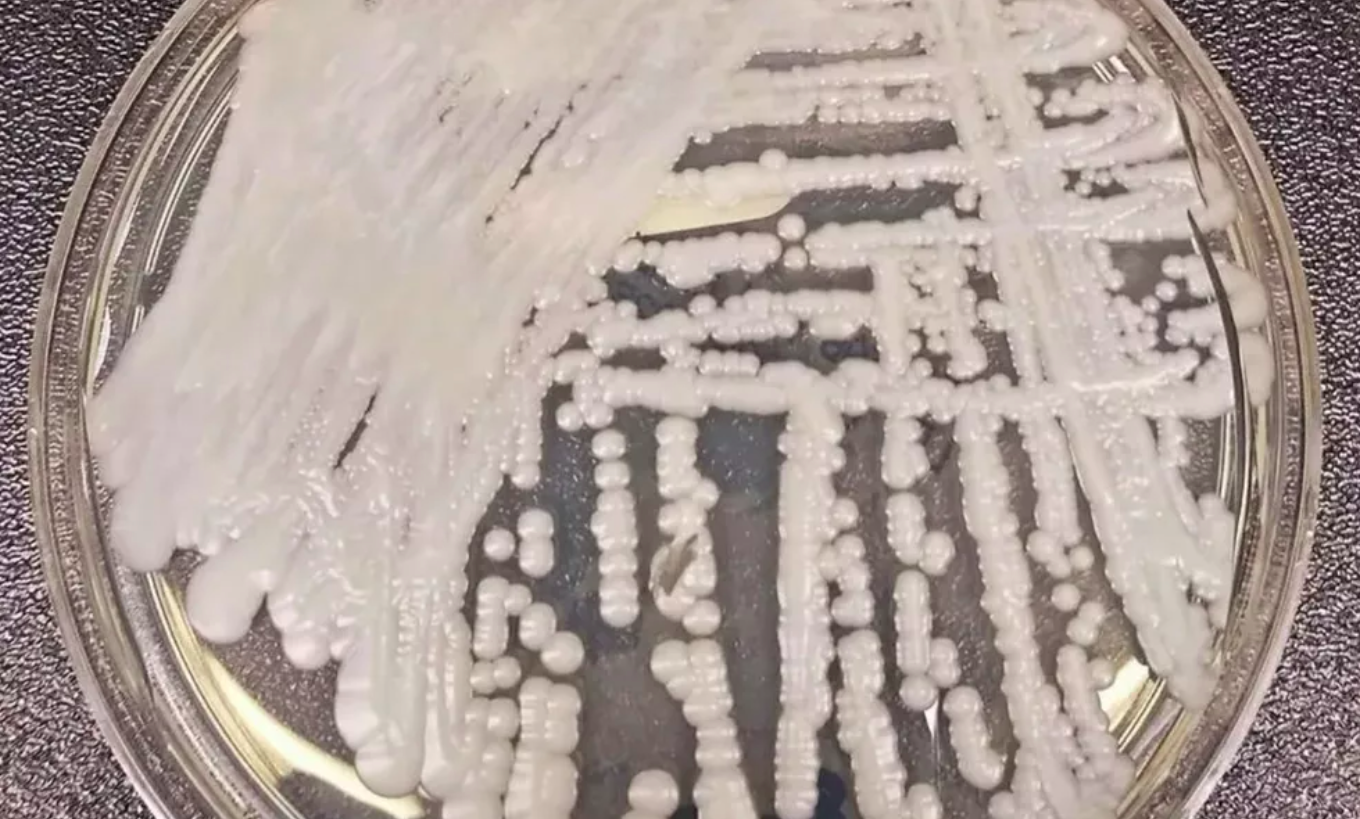

A Agência Nacional de Vigilância Sanitária (Anvisa) confirmou, segundo caso do “superfungo” Candida auris em Pernambuco nesta quinta-feira (13). O fungo é resistente a praticamente todos os medicamentos existentes. Sem uma análise especializada, ele pode ser confundido com vários outros tipos comuns.
Segundo a a Secretaria Estadual de Saúde (SES-PE), uma mulher de 70 anos admitida por questões neurológicas no Hospital da Restauração, no bairro do Derby, no Recife, no dia 24 de novembro foi diagnosticada com o fungo. E um homem de 38 anos que já teve alta do mesmo hospital. Um terceiro paciente com exame sugestivo para Candida auris segue em investigação.
A mulher que teve o resultado divulgado em novembro morreu no dia 5 de janeiro em decorrência dos problemas neurológicos e, apesar de estar com o fungo, não apresentou sintomas, segundo a secretaria. A constatação do fungo foi feita através de exame realizado pelo Laboratório Especial de Micologia da Escola Paulista de Medicina (LEMI – Unifesp).
Apesar de apenas dois casos terem sido confirmados, pode-se considerar que este é o terceiro surto de Candida auris no Brasil, já que a definição de surto não é apenas uma grande quantidade de casos, mas também o surgimento de um microrganismo novo na epidemiologia do país.
De acordo com a Anvisa, ainda não se sabe o mecanismo de transmissão, acreditando-se que é por meio de contato com superfícies ou equipamentos contaminados. Informando que a força tarefa nacional foi acionada e várias ações de vigilância, monitoramento, prevenção e controle foram intensificadas.
Fonte: G1 Santos